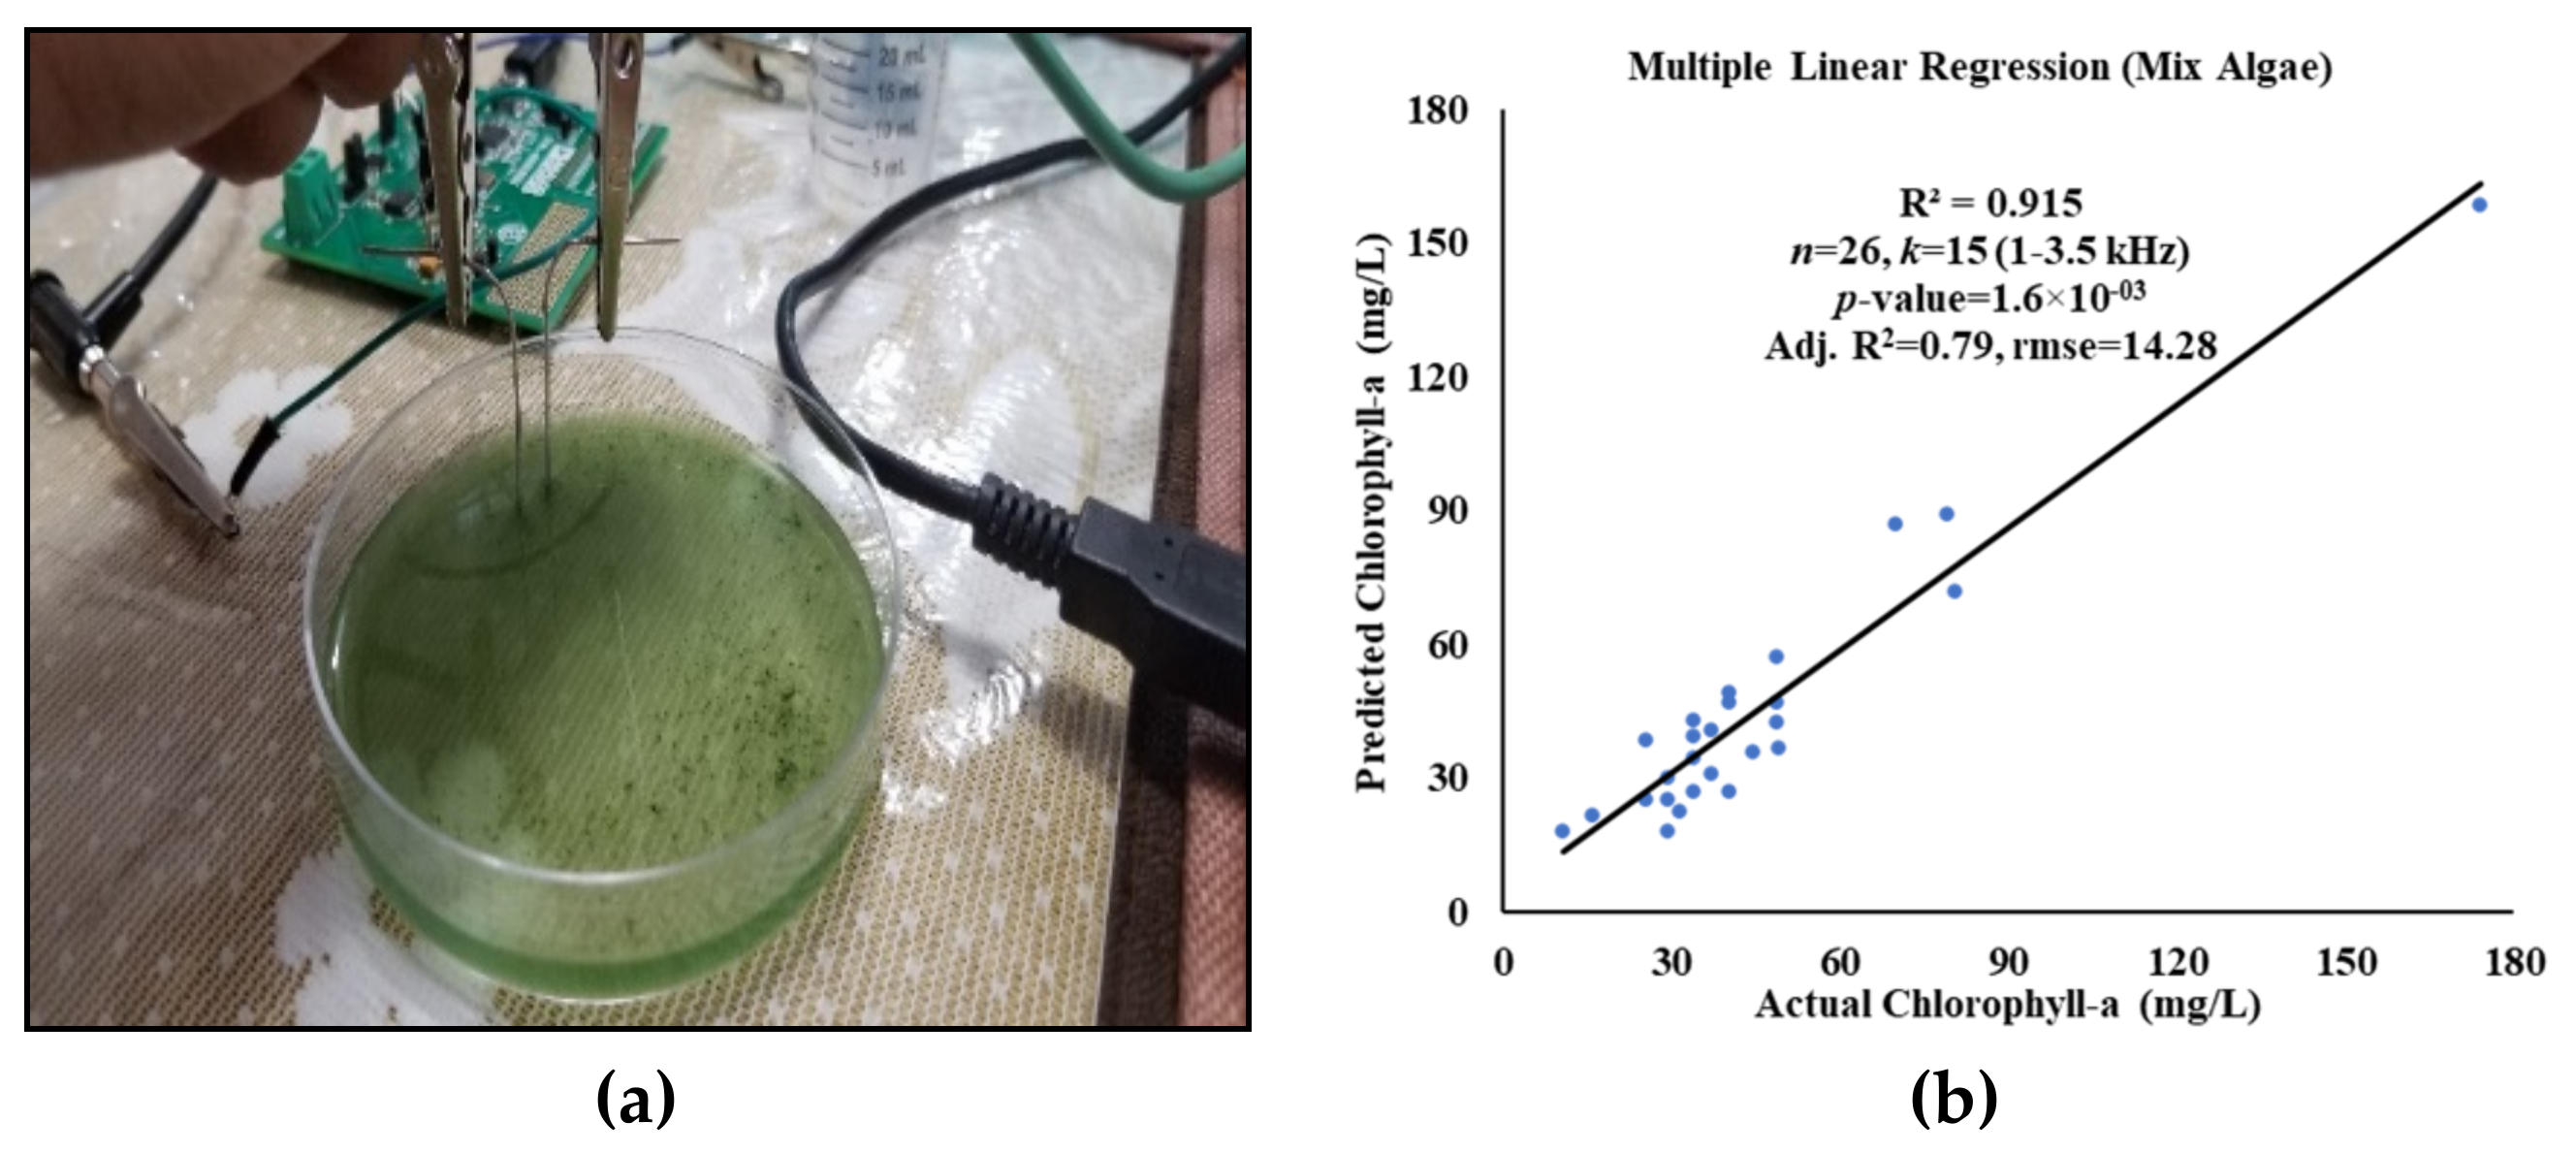
Water 13 01223 g007 Water 13 01223 g007

Estimation of the Chlorophyll-A Concentration of Algae Species Using Electrical Impedance Spectroscopy
Abstract
1. Introduction
2. Materials and Methods
2.1. Growing of Algae Species
2.2. Sample Preparation and Extracting Chlorophyll-a
2.3. Experimental Setup
2.4. Work Flow
3. Model Development and Result Analysis
3.1. Development of EIS Models
3.2. Validation of EIS Models
3.3. Performance Evaluation of the Sensor
4. Discussion
5. Conclusions
Author Contributions
Funding
Institutional Review Board Statement
Informed Consent Statement
Data Availability Statement
Acknowledgments
Conflicts of Interest
References
- Soni, R.A.; Sudhakar, K.; Rana, R.S. Spirulina—From growth to nutritional product: A review. Trends Food Sci. Technol. 2017, 69, 157–171. [Google Scholar] [CrossRef]
- Ndjouondo, G.P.; Dibong, S.D.; Wamba, F.O.; Taffouo, V.D. Growth, Productivity and Some Physico-chemical Factors of Spirulina platensis Cultivation as Influenced by Nutrients Change. Int. J. Bot. 2017, 13, 67–74. [Google Scholar] [CrossRef][Green Version]
- Nuhu, A.A. Spirulina (Arthrospira): An Important Source of Nutritional and Medicinal Compounds. J. Mar. Biol. 2013, 2013, 1–8. [Google Scholar] [CrossRef]
- He, L.; Chen, Y.; Wu, X.; Chen, S.; Liu, J.; Li, Q. Effect of Physical Factors on the Growth of Chlorella Vulgaris on Enriched Media Using the Methods of Orthogonal Analysis and Response Surface Methodology. Water 2020, 12, 34. [Google Scholar] [CrossRef]
- Metsoviti, M.N.; Papapolymerou, G.; Karapanagiotidis, I.T.; Katsoulas, N. Effect of Light Intensity and Quality on Growth Rate and Composition of Chlorella vulgaris. Plants 2020, 9, 31. [Google Scholar] [CrossRef]
- Enyidi, U.D. Chlorella vulgaris as Protein Source in the Diets of African Catfish Clarias gariepinus. Fishes 2017, 2, 1. [Google Scholar] [CrossRef]
- Saeid, A.; Chojnacka, K.W. Evaluation of Growth Yield of Spirulina maxima in Photobioreactors. Chem. Biochem. Eng. Q. 2016, 30, 127–136. [Google Scholar] [CrossRef]
- Barkallah, M.; Atitallah, A.B.; Hentati, F.; Dammak, M.; Hadrich, B.; Fendri, I.; Ayadi, M.A.; Michaud, P.; Abdelkaf, S. Effect of Spirulina platensis Biomass with High Polysaccharides Content on Quality Attributes of Common Carp (Cyprinus carpio) and Common Barbel (Barbus barbus) Fish Burgers. Appl. Sci. 2019, 9, 2197. [Google Scholar] [CrossRef]
- Quintero-Dallos, V.; García-Martínez, J.B.; Contreras-Ropero, J.E.; Barajas-Solano, A.F. Crisostomo Barajas-Ferrerira, Roberto Lavecchia and Antonio Zuorro, Vinasse as a Sustainable Medium for the Production of Chlorella vulgaris UTEX 1803. Water 2019, 11, 1526. [Google Scholar] [CrossRef]
- Chen, R.; Ju, M.; Chu, C.; Jing, W.; Wang, Y. Identification and Quantification of Physicochemical Parameters Influencing Chlorophyll-a Concentrations through Combined Principal Component Analysis and Factor Analysis: A Case Study of the Yuqiao Reservoir in China. Sustainability 2018, 10, 936. [Google Scholar] [CrossRef]
- Carlson, R.E. A Trophic State Index for Lakes. Limnol. Oceanogr. 1977, 22, 361–369. [Google Scholar] [CrossRef]
- Alemayehu, D.; Hackett, F. Water Quality and Trophic State of Kaw Lake. J. Environ. Stud. 2016, 2, 1–7. [Google Scholar]
- Balali, S.; Hoseini, S.A.; Ghorbani, R.; Balali, S. Correlation of Chlorophyll-A with Secchi Disk Depth and Water Turbidity in the International Alma Gol Wetland, Iran. World J. Fish. Mar. Sci. 2012, 4, 504–508. [Google Scholar]
- Lee, Z.P.; Shang, S.; Hu, C.; Du, K.; Weidemann, A.; Hou, W.; Lin, J.; Lin, G. Secchi disk depth: A new theory and mechanistic model for underwater visibility. Remote Sens. Environ. 2015, 169, 139–149. [Google Scholar] [CrossRef]
- Liu, X.; Lee, Z.; Zhang, Y.; Lin, J.; Shi, K.; Zhou, Y.; Qin, B.; Sun, Z. Remote Sensing of Secchi Depth in Highly Turbid Lake Waters and Its Application with MERIS Data. Remote Sens. 2019, 11, 2226. [Google Scholar] [CrossRef]
- Lee, S.; Lee, D. Improved Prediction of Harmful Algal Blooms in Four Major South Korea’s Rivers Using Deep Learning Models. Int. J. Environ. Res. Public Health 2018, 15, 1322. [Google Scholar] [CrossRef]
- Bawiec, A.; Garbowski, T.; Pawęska, K.; Pulikowski, K. Analysis of the Algae Growth Dynamics in the Hydroponic System with LEDs Nighttime Lighting Using the Laser Granulometry Method. Water Air Soil Pollut. 2019, 230, 1–11. [Google Scholar] [CrossRef]
- Prates, D.F.; Radmann, E.M.; Duarte, J.H.; Morais, M.G.; Costa, J.A.V. Spirulina cultivated under different light emitting diodes: Enhanced cell growth and phycocyanin production. Bioresour. Technol. 2018, 256, 38–43. [Google Scholar] [CrossRef]
- Fu, W.; Gudmundsson, O.; Feist, A.M.; Herjolfsson, G.; Brynjolfsson, S.; Palsson, B.Q. Maximizing biomass productivity and cell density of Chlorella vulgaris by using light-emitting diode-based photobioreactor. J. Biotechnol. 2012, 161, 242–249. [Google Scholar] [CrossRef] [PubMed]
- Soni, R.A.; Sudhakar, K.; Rana, R.S. Comparative study on the growth performance of Spirulina platensis on modifying culture media. Energy Rep. 2019, 5, 327–336. [Google Scholar] [CrossRef]
- Ak, I. Effect of an organic fertilizer on growth of blue-green alga Spirulina platensis. Aquacult. Int. 2012, 20, 413–422. [Google Scholar] [CrossRef]
- Mamun, M.; Kim, J.J.; Alam, M.A.; An, K.G. Prediction of Algal Chlorophyll-a and Water Clarity in Monsoon-Region Reservoir Using Machine Learning Approaches. Water 2020, 12, 30. [Google Scholar] [CrossRef]
- Keller, S.; Maier, P.M.; Riese, F.M.; Norra, S.; Holbach, A.; Börsig, N.; Wilhelms, A.; Moldaenke, C.; Zaake, A.; Hinz, S. Hyperspectral Data and Machine Learning for Estimating CDOM, Chlorophyll a, Diatoms, Green Algae and Turbidity. Int. J. Environ. Res. Public Health 2018, 15, 1881. [Google Scholar] [CrossRef]
- Deng, J.; Chen, F.; Hu, W.; Lu, X.; Xu, B.; Hamilton, D.P. Variations in the Distribution of Chl-a and Simulation Using a Multiple Regression Model. Int. J. Environ. Res. Public Health 2019, 16, 4553. [Google Scholar] [CrossRef]
- Delrue, F.; Alaux, E.; Moudjaoui, L.; Gaignard, C.; Fleury, G.; Perilhou, A.; Richaud, P.; Petitjean, M.; Sassi, J.F. Optimization of Arthrospira platensis (Spirulina) Growth: From Laboratory Scale to Pilot Scale. Fermentation 2017, 3, 59. [Google Scholar] [CrossRef]
- Ross, M.E.; Stanley, M.S.; Day, J.G.; Semião, A.J.C. A comparison of methods for the non-destructive fresh weight determination of filamentous algae for growth rate analysis and dry weight estimation. J. Appl. Phycol. 2017, 29, 2925–2936. [Google Scholar] [CrossRef] [PubMed]
- Agberien, A.V.; Örmeci, B. Monitoring of Cyanobacteria in Water Using Spectrophotometry and First Derivative of Absorbance. Water 2020, 12, 124. [Google Scholar] [CrossRef]
- Rodrigues, L.H.R.; Arenzon, A.; Raya-Rodriguez, M.T.; Fontoura, N.F. Algal density assessed by spectrophotometry: A calibration curve for the unicellular algae Pseudokirchneriella subcapitata. J. Environ. Chem. Ecotoxicol. 2011, 3, 225–228. [Google Scholar]
- Shin, Y.H.; Wing, M.T.G.; Choi, J.W. A field-deployable and handheld fluorometer for environmental water quality monitoring. Micro Nano Syst. Lett. 2018, 6, 1–6. [Google Scholar] [CrossRef]
- Jones, J.; Manning, S.; Montoya, M.; Keller, K.; Poenie, M. Extraction of Algal Lipids and Their Analysis by HPLC and Mass Spectrometry. J. Am. Oil Chem Soc. 2012, 89, 1371–1381. [Google Scholar] [CrossRef]
- Takahashi, T. Applicability of Automated Cell Counter with a Chlorophyll Detector in Routine Management of Microalgae. Sci. Rep. 2018, 8, 1–12. [Google Scholar] [CrossRef] [PubMed]
- Ng, C.L.; Chen, Q.Q.; Chua, J.J.; Hemond, H.F. A Multi-Platform Optical Sensor for In Vivo and In Vitro Algae Classification. Sensors 2017, 17, 912. [Google Scholar] [CrossRef] [PubMed]
- Jia, F.; Kacira, M.; Ogden, K.L. Multi-Wavelength Based Optical Density Sensor for Autonomous Monitoring of Microalgae. Sensors 2015, 15, 22234–22248. [Google Scholar] [CrossRef]
- Cheng, C.; Wei, Y.; Lv, G.; Xu, N. Remote sensing estimation of chlorophyll-a concentration in Taihu Lake considering spatial and temporal variations. Environ. Monit Assess. 2019, 191, 84. [Google Scholar] [CrossRef] [PubMed]
- Baek, J.Y.; Jo, Y.H.; Kim, W.; Lee, J.S.; Jung, D.; Kim, D.W.; Nam, J. A New Algorithm to Estimate Chlorophyll-A Concentrations in Turbid Yellow Sea Water Using a Multispectral Sensor in a Low-Altitude Remote Sensing System. Remote Sens. 2019, 11, 2257. [Google Scholar] [CrossRef]
- Wang, G.; Lee, Z.; Mouw, C. Multi-Spectral Remote Sensing of Phytoplankton Pigment Absorption Properties in Cyanobacteria Bloom Waters: A Regional Example in the Western Basin of Lake Erie. Remote Sens. 2017, 9, 1309. [Google Scholar] [CrossRef]
- Nowak, A.P.; Lisowska-Oleksiak, A.; Wicikowska, B.; Gazda, M. Biosilica from sea water diatoms algae-electrochemical impedance spectroscopy study. J. Solid State Electrochem. 2017, 21, 2251–2258. [Google Scholar] [CrossRef]
- Sui, J.; Fofonker, F.; Bhattacharya, D.; Javanmard, M. Electrical impedance as an indicator of microalgal cell health. Sci. Rep. 2020, 10, 1–9. [Google Scholar] [CrossRef]
- Rodrigues, L.S.; Valle, A.F.; D’Elia, E. Biomass of Microalgae Spirulina Maxima as a Corrosion Inhibitor for 1020 Carbon Steel in Acidic Solution. Int. J. Electrochem. Sci. 2018, 13, 6169–6189. [Google Scholar] [CrossRef]
- Mert, B.D.; Mert, M.E.; Kardas, G.; Yazici, B. The role of Spirulina platensis on corrosion behavior of carbon steel. Mater. Chem. Phys. 2011, 130, 697–701. [Google Scholar] [CrossRef]
- Benabbouha, T.; Siniti, M.; Attari, H.E.; Chefira, K.; Chibi, F.; Nmila, R.; Rchid, H. Red Algae Halopitys Incurvus Extract as a Green Corrosion Inhibitor of Carbon Steel in Hydrochloric Acid. J. Bio- Tribo-Corros. 2018, 4, 1–9. [Google Scholar] [CrossRef]
- Zhang, W.; Dixon, M.B.; Saint, C.; Teng, K.S.; Furumai, H. Electrochemical Biosensing of Algal Toxins in Water: The Current State-of-the-Art. ACS Sens. 2018, 3, 1233–1245. [Google Scholar] [CrossRef]
- Zhang, W.; Jia, B.; Furumai, H. Fabrication of graphene film composite electrochemical biosensor as a pre-screening algal toxin detection tool in the event of water contamination. Sci. Rep. 2018, 8, 1–10. [Google Scholar] [CrossRef] [PubMed]
- Ojarand, J.; Min, M.; Koel, A. Multichannel Electrical Impedance Spectroscopy Analyzer with Microfluidic Sensors. Sensors 2019, 19, 1891. [Google Scholar] [CrossRef]
- Liu, S.; Huang, Y.; Wu, H.; Tan, C.; Jia, J. Efficient Multi-Task Structure-Aware Sparse Bayesian Learning for Frequency-Difference Electrical Impedance Tomography. IEEE Trans. Ind. Inform. 2021, 17, 463–472. [Google Scholar] [CrossRef]
- Sapuan, I.; Yasin, M.; Ain, K.; Apsari, R. Anomaly Detection Using Electric Impedance Tomography Based on Real and Imaginary Images. Sensors 2020, 20, 1907. [Google Scholar] [CrossRef]
- Umar, L.; Setiadi, R.N. Low cost soil sensor based on impedance spectroscopy for in-situ measurement. Aip. Conf. Proc. 2015, 1656, 040005. [Google Scholar]
- Muñoz-Huerta, R.F.; Ortiz-Melendez, A.J.; Guevara-Gonzalez, R.G.; Torres-Pacheco, I.; Herrera-Ruiz, G.; Contreras-Medina, L.M.; Prado-Olivarez, J.; Ocampo-Velazquez, R.V. An analysis of electrical impedance measurements applied for plant N status estimation in lettuce (Lactuca sativa). Sensors 2014, 14, 11492–11503. [Google Scholar] [CrossRef]
- Meiqing, L.; Jinyang, L.; Xinhua, W.; Wenjing, Z. Early diagnosis and monitoring of nitrogen nutrition stress in tomato leaves using electrical impedance spectroscopy. Int. J. Agric. Biol. Eng. 2017, 10, 194–205. [Google Scholar]
- Kertész, A.; Hlaváčová, Z.; Vozáry, E.; Staroňová, L. Relationship between moisture content and electrical impedance of carrot slices during drying. Int. Agrophys. 2015, 29, 61–66. [Google Scholar] [CrossRef]
- Postic, F.; Doussan, C. Benchmarking electrical methods for rapid estimation of root biomass. Plant. Methods 2016, 12, 1–11. [Google Scholar] [CrossRef] [PubMed]
- Grossi, M.; Riccò, B. Electrical impedance spectroscopy (EIS) for biological analysis and food characterization: A review. J. Sens. Sens. Syst. 2017, 6, 303–325. [Google Scholar] [CrossRef]
- Juansah, J.; Budiastra, I.W.; Dahlan, K.; Seminar, K.B. The prospect of electrical impedance spectroscopy as non-destructive evaluation of citrus fruits acidity. IJETAE 2012, 2, 58–64. [Google Scholar]
- Basak, R.; Wahid, K.; Dinh, A. Determination of leaf nitrogen concentrations using electrical impedance spectroscopy in multiple crops. Remote Sens. 2020, 12, 566. [Google Scholar] [CrossRef]
- Basak, R.; Wahid, K.A.; Dinh, A.; Soolanayakanahally, R.; Fotouhi, R.; Mehr, A.S. Rapid and Efficient Determination of Relative Water Contents of Crop Leaves Using Electrical Impedance Spectroscopy in Vegetative Growth Stage. Remote Sens. 2020, 12, 1753. [Google Scholar] [CrossRef]
- Algae Research Supply. Available online: https://algaeresearchsupply.com/pages/measuring-growth (accessed on 21 October 2020).
- Brewin, R.J.W.; Brewin, T.J.; Phillips, J.; Rose, S.; Abdulaziz, A.; Wimmer, W.; Sathyendranath, S.; Platt, T. A Printable Device for Measuring Clarity and Colour in Lake and Nearshore Waters. Sensors 2019, 19, 936. [Google Scholar] [CrossRef]
- Quevedo-Castro, A.; Bandala, E.R.; Rangel-Peraza, J.G.; Amábilis-Sosa, L.E.; Sanhouse-García, A.; Bustos-Terrones, Y.A. Temporal and Spatial Study of Water Quality and Trophic Evaluation of a Large Tropical Reservoir. Environments 2019, 6, 61. [Google Scholar] [CrossRef]
- Sulis, A.; Buscarinu, P.; Soru, O.; Sechi, G.M. Trophic State and Toxic Cyanobacteria Density in Optimization Modeling of Multi-Reservoir Water Resource Systems. Toxins 2014, 6, 1366–1384. [Google Scholar] [CrossRef]
- Malone, E.; Santos, G.S.D.; Holder, D.; Arridge, S. Multifrequency Electrical Impedance Tomography Using Spectral Constraints. IEEE Trans. Med Imaging 2014, 33, 340–350. [Google Scholar] [CrossRef]
- Chowdhury, R.I.; Basak, R.; Wahid, K.A.; Nugent, K.; Baulch, H. A Rapid Approach to Measure Extracted Chlorophyll-a from Lettuce Leaves using Electrical Impedance Spectroscopy. Water Air Soil Pollut. 2021, 232, 1–12. [Google Scholar] [CrossRef]
- Michael, A.; Kyewalyanga, M.S.; Lugomela, C.V. Biomass and nutritive value of Spirulina (Arthrospira fusiformis) cultivated in a cost-effective medium. Ann. Microbiol. 2019, 69, 1387–1395. [Google Scholar] [CrossRef]
- Wang, Y.; Qu, T.; Zhao, X.; Tang, X.; Xiao, H.; Tang, X. A comparative study of the photosynthetic capacity in two green tide macroalgae using chlorophyll fluorescence. SpringerPlus 2016, 5, 1–12. [Google Scholar] [CrossRef] [PubMed]

| Test Samples of Algae Species | True Chlorophyll-a Using Equation (2) | Estimated Chlorophyll-a Using EIS | Percentage Accuracy | |
|---|---|---|---|---|
| Spirulina | 22.3 mg/L | 25.5 mg/L | 3.2 mg/L | 85.7% |
| Chlorella | 3.2 mg/L | 3.7 mg/L | 0.5 mg/L | 84.4% |
| Mix Algae | 61.5 mg/L | 57.9 mg/L | 3.6 mg/L | 94.1% |
| Excitation Source | Response | Detector | Cost | Operating Time | Accuracy (Affecting Factors) | |
|---|---|---|---|---|---|---|
| Spectrophot-ometry [27,28] | LED/Laser (lower sensitivity) | absorbance | photodiode | expensive | approx. 2–3 min (lab) | accurate (optical distortion) |
| Fluorometry [29] | LED/Laser (higher sensitivity than spectro) | fluorescence | photodiode | more than spectro | approx. 5–6 min (lab) | more accurate than spectro |
| HPLC [30] | Laser (highly sensitive) | fluorescence | photodiode | highly expensive | approx. 15–20 min (lab) | highly accurate |
| Hemocytom-etry [31] | LED (sensitive to cell counts) | no. of cells | counting chamber | higher than EIS | approx. 5–10 min (lab) | accurate (miscounts large cells) |
| Multispectral Imaging [34,35,36] | LED (wavelength sensitivity) | reflectance | sensor probes | higher than EIS | approx. 1–2 min (in situ) | Accurate (data losses) |
| EIS (This Work) | voltage (frequency sensitivity) | impedance | electrodes | low cost | approx. 1 min (in situ) | Accurate (model-dependent) |
Publisher’s Note: MDPI stays neutral with regard to jurisdictional claims in published maps and institutional affiliations. |
© 2021 by the authors. Licensee MDPI, Basel, Switzerland. This article is an open access article distributed under the terms and conditions of the Creative Commons Attribution (CC BY) license (https://creativecommons.org/licenses/by/4.0/).
Share and Cite
Basak, R.; Wahid, K.A.; Dinh, A. Estimation of the Chlorophyll-A Concentration of Algae Species Using Electrical Impedance Spectroscopy. Water 2021, 13, 1223. https://doi.org/10.3390/w13091223
Basak R, Wahid KA, Dinh A. Estimation of the Chlorophyll-A Concentration of Algae Species Using Electrical Impedance Spectroscopy. Water. 2021; 13(9):1223. https://doi.org/10.3390/w13091223
Chicago/Turabian StyleBasak, Rinku, Khan A. Wahid, and Anh Dinh. 2021. "Estimation of the Chlorophyll-A Concentration of Algae Species Using Electrical Impedance Spectroscopy" Water 13, no. 9: 1223. https://doi.org/10.3390/w13091223
APA StyleBasak, R., Wahid, K. A., & Dinh, A. (2021). Estimation of the Chlorophyll-A Concentration of Algae Species Using Electrical Impedance Spectroscopy. Water, 13(9), 1223. https://doi.org/10.3390/w13091223

